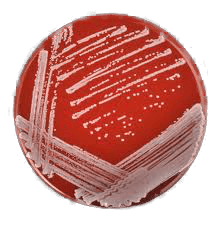
caja de petri de dibico

METODOLOGÍAS PARA VERIFICAR LA CALIDAD DE LIMPIEZA Y SANITIZADO EN LAS LÍNEAS DE PRODUCCIÓN DE ALIMENTOS.
En la producción de alimentos es de suma importancia conocer el nivel de higiene de las áreas de producción después de haber realizado el sanitizado y lavado y antes de empezar la fabricación. Se debe tener la certeza de que la sanitización y el lavado haya sido el apropiado para no contaminar el producto ya que representa un riesgo real para la salud humana, se reduce considerablemente su vida de anaquel, genera pérdidas económicas y puede dañar el prestigio y la imagen del fabricante.
Existen diferentes metodologías para monitorear el nivel de higiene de las líneas de producción:
- El análisis organoléptico
- El sembrado en placa
- Los luminómetros o equipos de bioluminscencia
ANÁLISIS ORGANOLÉPTICO
Este método se basa en la observación del personal para saber si las líneas de producción "se ven limpias"; es muy poco confiable ya que ni las bacterias ni el material orgánico se pueden ver a simple vista.
SEMBRADO EN PLACA
Este procedimiento nos da una idea de la concentración de bacterias que quedan después de la sanitización y el lavado; pero este método además de ser lento, toma por lo menos 24 hs. para saber los resultados y solamente mide la concentración de bacterias y no la cantidad de material orgánico que sirve de alimento para los microorganismos, promoviendo con esto el crecimiento exponencial de la población bacteriológica poniendo con esto en grave riesgo la calidad de los productos que se producen.
LUMINÓMETRO (O EQUIPO DE BIOLUMINISCENCIA)
El luminómetro tiene muchas ventajas. Ofrece resultados entre un rango de 10 a 15 seg. dependiendo del equipo, y esto permite decidir casi inmediatamente si se deberá limpiar y sanitizar de nuevo la línea antes de empezar la producción de alimentos. Además el luminómetro permite almacenar en la memoria del equipo los resultados obtenidos para posteriormente analizarlos en una computadora mediante un programa de gestión de información.
PRINCIPIO EN QUE SE BASAN LOS LUMINÓMETROS QUE UTILIZAN LA TB (TECNOLOGÍA DE BIOLUMINISCENCIA)
La tecnología de bioluminiscencia está basada en una reacción química donde es necesaria la proteína "luciferina" en presencia de la enzima catalizadora "luciferasa", donde junto con la molécula energética trifosfato de adenosina (ATP), que es la molécula que se encuentra en todo compuesto orgánico, incluidos los alimentos, se crea la reacción de luz.
BACTERIAS Y RESIDUOS CONTIENEN ATP
Cuando se lleva a cabo el procedimiento de sanitización y lavado en las líneas de producción de las plantas de alimentos el objetivo primordial es eliminar todas las bacterias y/o residuos de alimentos para con esto asegurar que los alimentos a producir no serán contaminados. La mayor parte de estas bacterias, vivas y muertas, así como todo material orgánico, como los residuos de alimentos, contienen una determinada cantidad de ATP (Adenosina Trifosfato).
- Rapidez en obtener resultados de limpieza (menos de un minuto
- Precisión y confiabilidad en los resultados
- Permite evaluar el plan de limpieza
- Coadyuva con el Programa HACCP para el aseguramiento de la limpieza
- Manejo sencillo
- Ahorro en consumo de sanitizantes
- Ahorro de materiales y reactivos
- Practicidad para evaluar las áreas
- Los datos pueden ser graficados

DIFERENCIAS DE RESULTADOS QUE TIENE LA TECNOLOGÍA DE BIOLUMINISCENCIA Y EL MÉTODO TRADICIONAL.
Los resultados obtenidos mediante el método tradicional no permiten graficarse de manera precisa, ya que es por conteo de cepas de bacterias, en unidades formadoras de colonias (UFC), identificar el tipo de microorganismo por medio de sus características de crecimiento, forma, color, turbidez, etc.
Después de realizar la siembra e inoculación, los resultados por el método tradicional toman mínimo 24 horas para poder ser analizados, por el tiempo de la incubación.
La obtención de resultados por el método de bioluminiscencia es de manera directa, toma menos de un minuto para obtener los resultados, indicando si la superficie muestreada se encuentra limpia o no, los resultados son almacenados en los equipos y pueden ser descargados en una computadora para realizar graficas, visualizar los puntos críticos de control, evaluar el plan de saneamiento y facilitar tomar un plan de acción.
¿POR QUÉ EL MÉTODO TRADICIONAL NO SE CORRELACIONA CON EL MÉTODO DE BIOLUMINISCENCIA?
El método tradicional (MT) requiere de diferente instrumental, así como reactivos para poder llevar acabo el procedimiento, éste método requiere de mayor tiempo para poder obtener los resultados. Además el MT contabiliza los microrganismos viables (MV) y no toma en cuenta los residuos orgánicos (RO). Los equipos de Bioluminiscencia contabilizan el ATP que se encuentra presente en los MV y en los RO.
El método de bioluminiscencia no requiere de mucho instrumental ni de tantos reactivos, solamente se requiere un luminómetro e hisópos de muestreo, los hisópos ya contienen la solución amortiguadora correspondiente que extrae el ATP y el equipo puede cuantificar la cantidad de ATP como una medida directa de la cantidad de MV y los RO.

IMPORTANCIA DE LA UTILIZACIÓN DE LA TECNOLOGÍA DE BIOLUMINISCENCIA EN LA INDUSTRIA ALIMENTARIA.
La tecnología de bioluminiscencia se utiliza como herramienta para facilitar a los gestores de calidad el análisis de limpieza y el programa de saneamiento de las líneas de producción y equipos en contacto con la materia prima y producto terminado, incorporándose en el programa de monitoreo de Análisis de Riesgo y Puntos Críticos de Control (HACCP).
APLICACIÓN DE LA TECNOLOGÍA DE BIOLUMINISCENCIA EN LA INDUSTRIA ALIMENTARIA.
La tecnología de bioluminiscencia se aplica mediante la toma de muestras para analizar superficies o sistemas CIP con hisópos, los cuales, al momento de hacer un hisopado, frotando el hisopo sobre una superficie, recoge tanto trazas (o residuos) de alimentos como de microrganismos viables, luego del muestreo, el hisopo utilizado se ingresa en el luminómetro y se procede para que el equipo realize la lectura, en cuestión de segundos determinará los resultados en unidades "URL" (Unidades Relativas de Luz) o en zonas de limpieza según el grado de limpieza del área muestreada.
